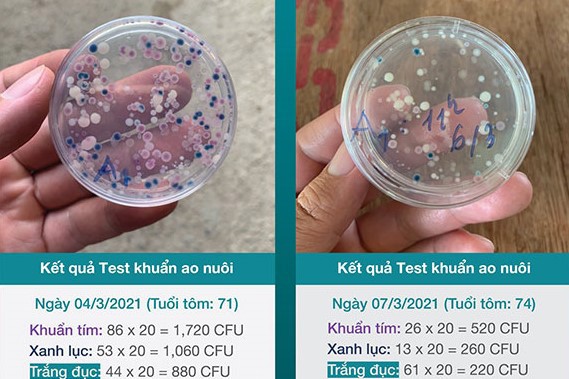

Chất lượng nước phụ thuộc vào nhiều yếu tố môi trường như hàm lượng vật chất hữu cơ, nồng độ ammonia và nitrite, ngưỡng oxy, pH, khoáng chất, nhiệt độ, … Các yếu tố này được cân bằng thì hệ sinh thái nước sẽ ổn định và người nuôi dễ dàng quản lý hơn.
Tưng bừng ưu đãi tháng mới cùng Vi sinh cao cấp AOcare
Skretting xin trân trọng thông báo chương trình đặc biệt dành cho sản phẩm Vi sinh cao cấp AOcare của Skretting từ 01/07/2021 đến 31/08/2021 như sau: Khi mua 2kg (10 gói) Vi sinh cao cấp AOcare Quý khách hàng sẽ được tặng thêm 200g (1 gói) Vi sinh cao câp AOcare (Lưu ý: Quý khách hàng có thể cộng dồn số gói hoặc kg đủ 10 gói hoặc 2kg AOcare để nhận 200 g (1 gói) AOcare. Chương trình không được qui đổi thành tiền mặt và chỉ có hiệu lực trong thời gian khuyến mãi).

Giải pháp hàng đầu cho mô hình nuôi tôm thâm canh và siêu thâm canh là quản lý tốt chất lượng nước. Ao nuôi chứa rất nhiều lợi khuẩn hỗ trợ tăng cường hệ miễn dịch và khả năng tiêu hóa cho đàn. Nhiệm vụ chính của các sản phẩm vi sinh là thúc đẩy lợi khuẩn phát triển và cân bằng tỷ lệ tảo, vi khuẩn. Đây là nền tảng để phân hủy các chất hữu cơ, thành phần độc tích tụ trong quá trình sản xuất. Kiểm soát ổn định hệ sinh thái trong ao, cân bằng các chỉ tiêu chất lượng ao nuôi, đảm bảo an toàn sinh học, tạo ra một môi trường bền vững là điều cần thiết.
Hiểu được giá trị này, Skretting đã cho ra mắt sản phẩm Vi sinh xử lý nước với hàm lượng lợi khuẩn và hiệu quả sử dụng vượt trội. Ngoài hiệu quả vượt trội đến từ khả năng phân hủy mùn bã hữu cơ, hấp thu khí độc, Vi sinh cao cấp Aocare còn thể hiện khả năng đặc biệt trong việc ức chế các chủng vi khuẩn có hại như Vibrio, Pseudomonas, Aeromonas, Streptococcus, Allococcus, Myxobacterium, Columnaris ESC và vi khuẩn gram âm gây bệnh khác. Khả năng thích nghi với nhiều loại môi trường khác nhau cũng là một trong những đặc tính vượt bậc giúp đảm bảo hiệu quả ổn định của sản phẩm
Hàm lượng lợi khuẩn và độ tinh khiết vượt trội
Hàm lượng cam kết cũng như độ tinh khiết của sản phẩm vi sinh là một trong những tiêu chí đầu tiên người nuôi cần quan tâm khi lựa chọn các giải pháp sinh học. Đến với Vi sinh cao cấp AOcare, hàm lượng Bacillus tổng số (bao gồm B. amyloliquefaciens, B. pumilus, B. subtilis) cam kết đạt tối thiểu 1.5 tỉ đơn vị hình thành khuẩn lạc trong mỗi gram sản phẩm (hay 1.5 x 109 cfu/g). Bên cạnh đó, sản phẩm còn bao gồm cả lợi khuẩn Pediococcus acidilactici với hàm lượng trên 1 tỉ đơn vị hình thành khuẩn lạc trong mỗi gram sản phẩm (hay 1.0 x 109 cfu/g).


Hỗn hợp các chủng có lợi được tuyển chọn chặt chẽ
Các chủng vi khuẩn Bacillus có trong Vi sinh cao cấp AOcare được tuyển chọn với những khả năng: hấp thu khí độc, phân hủy mùn bã hữu cơ, và ức chế vi khuẩn gây bệnh.
Nguồn Nitrogen trong ao nuôi được tạo thành từ quá trình bài tiết của động vật nuôi, mùn bã hữu cơ có trong nước, xác thủy sinh vật, từ đáy ao nuôi chưa được xử lý sạch và thức ăn thừa. Vi khuẩn có trong Vi sinh cao cấp AOcare sẽ chuyển hóa Ammonia (NH4+/NH3) thành các protein của tế bào chúng, từ đó làm giảm lượng ammonia. Ngoài ra, khi ammonia được duy trì ở ngưỡng cho phép sẽ tạo điều kiện cho các chủng Nitrosomonas và Nitrobacter có thời gian để phát triển. Do đó, hạn chế được sự xuất hiện của khí độc NO2. Các chủng vi khuẩn có trong AOcare được tuyển chọn với khả năng tiết các enzym ngoại bào (amylase, cellulase, protease), góp phần vào quá trình phân giải chất hữu cơ (chất thải, mùn bã và thức ăn dư thừa), nhờ đó nâng cao quản lý chất thải lắng tụ, hạn chế sự hình thành khí độc H2S trong ao nuôi.
Ngoài hoạt động xử lý sinh học, các chủng vi khuẩn có lợi trong Vi sinh cao cấp AOcare còn được tuyển chọn với khả năng cạnh tranh môi trường sống, dinh dưỡng, bề mặt bám, và sản sinh các hoạt chất sinh học lấn át sự phát triển của các chủng vi khuẩn gây bệnh. Đặc biệt, chủng Pediococcus acidilactici có khả năng ức chế trực tiếp lên chủng Vibrio parahaemolyticus (tác nhân cho bệnh EMS).

Khuyến nghị sử dụng
Để tối ưu hóa hiệu quả của sản phẩm, liều lượng sử dụng thích hợp với từng giai đoạn trong quy trình nuôi, điều kiện ao nuôi là một trong những yếu tố cần được quan tâm hàng đầu. Liệu lượng sử dụng Vi sinh AOcare cho từng giai đoạn và mật độ thả nuôi:
|
Mật độ tôm |
|||
Mật độ thả tôm (con/m2) |
Liều g/1000m3 |
< 60 con/m2 |
60 - 150 con/m2 |
> 150 con/m2 |
Trước khi thả tôm |
100 |
1 lần |
||
Tháng thứ nhất sau khi thả tôm |
30 |
7 ngày/lần |
5 ngày/lần |
3 ngày/lần |
Tháng thứ hai sau khi thả tôm |
40 |
|||
Tháng thứ ba sau khi thả tôm |
50 |
*Tăng liều gấp đôi khi điều kiện môi trường nhạy cảm
Môi trường nước sạch giúp người nuôi đạt lợi nhuận tối đa và sức khỏe vật nuôi được tốt nhất. Vi sinh cao cấp AOcare là sản phẩm vi sinh xử lý nước cao cấp. Một khi chất lượng nước tốt, tôm, cá sẽ có tốc độ tăng trưởng và chuyến hóa thức ăn cao. Sử dụng Vi sinh cao cấp AOcare góp phần tối ưu hóa năng suất vụ nuôi nhờ tác động vào nước, thức ăn, sức khỏe và quản lý ao nuôi.

Chương trình ưu đãi tri ân khách hàng
Skretting xin trân trọng thông báo chương trình đặc biệt dành cho sản phẩm Vi sinh cao cấp AOcare của Skretting từ 01/07/2021 đến 31/08/2021 như sau:
Khi mua 2kg (10 gói) Vi sinh cao cấp AOcare Quý khách hàng sẽ được tặng 200g (1 gói) Vi sinh cao câp AOcare
*Quý khách hàng có thể cộng dồn số gói hoặc kg đủ 10 gói hoặc 2kg AOcare để nhận 200 g (1 gói) AOcare.
**Chương trình không được qui đổi thành tiền mặt và chỉ có hiệu lực trong thời gian khuyến mãi.